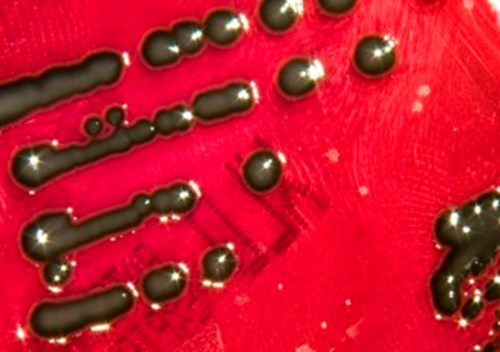
Salmonella
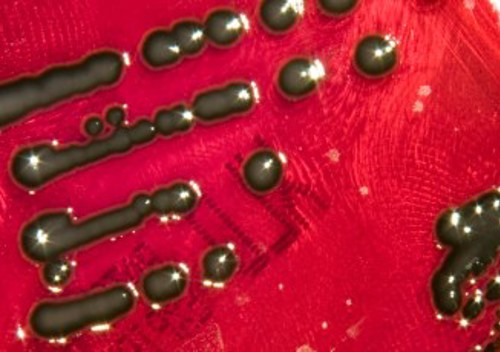
Salmonella

NCTC zoonotic pathogens: Salmonella bongori
While a less prolific pathogen than Salmonella enterica subspecies and mainly associated with infection of cold-blooded animals, Salmonella bongori is capable of infection warm-blooded animals including humans.
Alongside the type strain of the species, NCTC 12419 Salmonella bongori, additional strains of Salmonella bongori are available from the NCTC, including five newly accessions strains of differing sequence types kindly deposited by Public Health England’s Gastrointestinal Bacteria Reference Unit.
NCTC No. |
Organism |
Sequence Type |
---|---|---|
Salmonella bongori |
3196 |
|
Salmonella bongori |
7110 |
|
Salmonella bongori |
4397 |
|
Salmonella bongori |
395 |
|
Salmonella bongori |
395 |
Written by Jake D. Turnbull
Follow Jake on twitter @HotchPotchJake
October 2020